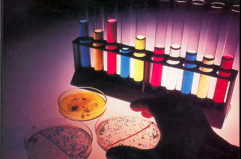
Scontro frontale nella sanit&agrave;, arriva lo stop ai centri prelievi di Martano e Campi Salentina

BARI - Avrebbe deciso di non denunciare e sviare le indagini sull'uomo che aveva molestato sua figlia, che all’epoca aveva 10 anni, in cambio di 600 euro ed è finita sotto inchiesta per favoreggiamento. Ora la donna, che vive nella provincia di Lecce, ha patteggiato una condanna a otto mesi di reclusione (pena sospesa e non menzione).
L’uomo accusato delle molestie è invece a processo con rito abbreviato con l’accusa di violenza sessuale aggravata. La notizia è riportata da alcuni quotidiani locali.
I fatti risalgono al 2020. Secondo l’accusa il molestatore avrebbe sottoposto la bambina ad abusi sessuali mentre erano al mare a Porto Cesareo. La bambina si sarebbe poi confidata con una insegnante e successivamente con la madre. Quest’ultima però, convocata in caserma, avrebbe tentato di sviare le indagini accusando un altro parente mai identificato.
Questo perchè, secondo l’accusa, aveva ricevuto 600 euro dal molestatore affinché non lo denunciasse. Le indagini hanno poi individuato l’uomo che è ora a processo.